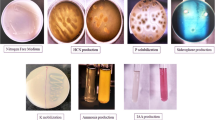

Abstract
Studies were conducted on the production of Bacillus thuringiensis (Bt)-based biopesticides to ascertain the performance of the process in shake flasks, and in two geometrically similar fermentors (15 and 150 l) utilizing wastewater sludge as a raw material. The results showed that it was possible to achieve better oxygen transfer in the larger capacity fermentor. Viable cell counts increased by 38–55% in the bioreactor compared to shake flasks. As for spore counts, an increase of 25% was observed when changing from shake flask to fermentor experiments. Spore counts were unchanged in bench (15 l) and pilot scale (5.3–5.5 e+08 cfu/ml; 150 l). An improvement of 30% in the entomotoxicity potential was obtained at pilot scale. Protease activity increased by two to four times at bench and pilot scale, respectively, compared to the maximum activity obtained in shake flasks. The maximum protease activity (4.1 IU/ml) was obtained in pilot scale due to better oxygen transfer. The Bt fermentation process using sludge as raw material was successfully scaled up and resulted in high productivity for toxin protein yield and a high protease activity.
Similar content being viewed by others
Explore related subjects
Discover the latest articles, news and stories from top researchers in related subjects.Avoid common mistakes on your manuscript.
Introduction
The production of Bacillus thuringiensis (Bt)-based biopesticides using wastewater sludge as a raw material has been successfully achieved in our laboratory [20, 25, 28, 29, 32, 33]. All these latter studies were conducted in shake flasks and/or bench scale bioreactors (10 l working volume). However, in order to develop suitable technology for possible commercialization, it was essential to carry out tests in pilot fermentors.
The purpose of scale-up is the selection of design conditions and operational procedures to ensure that the effect of different variables on the process is the same in units of different size. The final objective is to bring a fermentation process to its economic fruition, and therefore the technical aspects are important in so far as they can be translated into economic indicators such as yield, productivity, capital investment, and unit production cost, the combined evaluation of which eventually decides the economic viability of the process. Up-scaling fermentation processes from lab-scale to commercial units is challenging due to the difficulty in assessing the factors affecting the scale-up process during cultivation. It is well known that microorganisms are more susceptible to environmental variables, such as pH, temperature, dissolved oxygen (DO) and composition of raw materials, at large scale. These variables have a substantial effect on cell growth and metabolite production [13]. Also, particular attention must be paid to the oxygen transfer rate (OTR) and heat transfer rate. It is critical to ensure that, at large scale cultivation, the Bt process has adequate oxygen transfer and cooling capacity [35]. Other operational factors can and do change in scale-up, such as quality of mixing, shear stress, selection of cheaper media, foam control, physiological state of the inoculum, and sterilization of culture medium [14].
To ensure successful scale-up of fermentation processes, it is essential to determine appropriate scale-up criteria and the factors that reflect critical parameters of the fermentation process. Bt fermentation is a strong aerobic fermentation. The most utilized criteria for scale-up of aerobic fermentations maintaining geometric similarity are based on empirical or semi-empirical equations, which correlate the volumetric oxygen transfer coefficient (KLa) and the volumetric airflow rate per unit working volume (Q/V). Geometric similarities are the ratio between liquid height and vessel diameter, or the ratio between impeller diameter and vessel diameter. Geometric similarity is important from the practical point of view, in that it simplifies prediction of large-scale fermentor performance [16].
The primary aim of our investigation was to ensure reproducibility of results obtained at bench (15 l) and pilot (150 l) scale. Reproducible results are vital to a systematic analysis of the influence of process development parameters on fermentation performance on a large scale.
Materials and methods
Bacillus thuringiensis strain
B. thuringiensis var. kurstaki HD-1 (ATCC 33679) (Btk) was obtained from ATCC and maintained in the Canadian Forestry Service Lab (Ste-Foy, QC, Canada). An active culture was maintained by streak inoculating nutrient agar slant plates [tryptic soy agar (TSA) = 3.0% (v/v) tryptic soya broth (TSB; Difco, Detroit, Mich.) +1.5% Bacto- agar (Difco)], incubating at 30°C for 48 h and then storing at 4°C for future use.
Inoculum preparation
The inoculum was prepared in two steps as reported by Lachhab et al. [20]. Aliquots of bacteria from the slant were used to inoculate 500 ml Erlenmeyer flasks containing 100 ml sterilized TSB (3% v/v). After 8–12 h incubation at 30°C under shaking conditions (250 rpm), 2% (v/v) of this broth was used as seed culture to inoculate an Erlenmeyer flask containing the same medium (sludge in this case) as used for Bt fermentation. The flasks were then incubated in a rotary shaking incubator at 30°C with an agitation speed of 250 rpm for about 10–14 h. All the media used for inoculum preparation were adjusted to pH 7 before autoclaving. Finally, a 2% (v/v) inoculum of the actively growing cells (in exponential phase) of the pre-culture was transferred to the experimental shake flask and fermentor.
Raw material
Secondary sludge from a wastewater treatment plant [Communauté Urbaine du Quebec (CUQS)] was used (Table 1). The sludge was allowed to settle to increase the solids concentration to 25 g/l.
The physical characteristics of the sewage sludge, such as total sludge solids (TS), volatile solids (VS), suspended solids (SS) and volatile suspended solids (VSS), were determined according to standard methods [4]. The chemical characteristics of the sludge, such as total carbon and nitrogen, were analyzed with an NA 1500-NCS analyser (Carlo Erba, Milan, Italy). Other chemical components in the sludge, e.g., ammonical nitrogen, total phosphorus and phosphate as PO4, were analysed with a Technicon Analyser II (Technicon, Tarrytown, N.Y.). Metal (Al, Cd, Cr, Cu, Fe, Mn, Pb, Zn, Mg and Ca) concentrations were analysed by atomic absorption spectrometry using a Spectra AA-20 (Varian Techtron, Springvale, Victoria, Australia).
Fermentation procedure
Shake flask experiment
A 2% (v/v) inoculum of the pre-culture was used to inoculate a 500 ml Erlenmeyer flask containing 100 ml sterilized sludge. The flask was then incubated at 30°C±1 in a shaking incubator at 250 rpm for 48 h.
Bench and pilot-scale fermentor
Fermentations were carried out in two stirred-tank bioreactors—bench- and pilot-scale—with accessories and automatic control systems for DO, pH, antifoam, impeller speed, aeration rate and temperature. Details of fermentor dimensions are summarized in Table 2. The computer program used (Fix 5.5; Intellution, Norwood, Mass.) allowed automatic set-point control and registration of all stated parameters.
Before each sterilization cycle, the pH-electrode was calibrated using buffers of pH 7 and 4 (VWR, Mississauga, ON, Canada). The DO probe was calibrated to zero (with 1 N sodium sulfite solution) and 100% (saturated with air). Sludge was added to the fermentor, and polypropylene glycol (PPG; Sigma, Oakville, ON, Canada) (0.1% v/v) solution was added to control foam during sterilization. The fermentor was then sterilized in situ at 121°C for 30 min. After sterilization, the fermentor was cooled to 30°C. The DO probe was recalibrated to zero by sparging N2 gas, and to 100% saturation by sparging air at maximum agitation rate (150 rpm for pilot-scale fermentor and 500 rpm for bench-scale fermentor). The fermentor was then inoculated (2% v/v inoculum) with actively growing cells of the pre-culture. Fermentations were carried out under constant volumetric airflow rate per unit volume (Q/V=0.3 vvm). The agitation speed was varied to maintain DO values above 20% of saturation, which ensured oxygen concentrations above the critical level [6]. We found that if the oxygen concentration is allowed to decrease below 20–24% of saturation, the entomotoxicity value was markedly reduced (data not shown). The temperature was controlled at 30°C±1 by circulating hot or cold water through the jacket using a circulation pump. The pH was controlled at 7.0±0.1 using either 4 N NaOH or 6 N H2SO4 via computer-controlled peristaltic pumps. Foaming during fermentation was controlled using both a mechanical foam breaker and a chemical antifoam agent (PPG in 1:10 aqueous emulsion). DO and pH were continuously monitored by means of polarographic DO probe (Mettler Toledo, Newark, Del.) and pH sensor (Mettler Toledo) respectively. Samples were collected periodically to monitor changes in total viable cells (VC), spore count (SC), proteolytic activity (PA) and entomotoxicity (Tx).
Estimation of cell and spore count
To determine VC and SC, samples were serially diluted with sterile saline solution (0.85% NaCl). Appropriately diluted samples (0.1 ml) were plated on TSA plates and incubated at 30°C for 24 h to form fully developed colonies. For SC, appropriately diluted samples were heated in a silicone bath at 80°C for 10 min and then chilled on ice for 5 min [31]. This heat/cold shock lysed the vegetative cells and liberated those spores already formed in the bacterial cells [34]. VC and SC titers were estimated by counting colonies grown on nutrient medium. For all counts, the average of at least three replicate plates was used for each dilution tested. For enumeration, 30–300 colonies were counted per plate. The results were expressed in colony forming units per milliliter (cfu/ml). In order to establish the reliability and reproducibility of the plate count technique, ten independent samples were drawn (at the same time) from the shake flask experiment and were serially diluted and plated. Each dilution was plated on three different plates, colonies were counted and the standard deviation calculated. The standard deviation thus calculated was 6%.
Bioassay
The Tx of the fermentation products was measured by bioassay as the relative mortality to spruce budworm larvae (Choristoneura fumiferana, Lepidoptera: Torticidae; responsible for the destruction of conifer forests) induced by the fermentation product compared to that induced by the standard preparation Foray 76B (Abbott Labs, Chicago, Ill.). Bioassays were carried out using the diet incorporation method [7]. In this technique, 1.5 ml of serially decimal diluted sample was mixed with 30 ml molten (usually 55°C) agar-based diet and distributed into 20 bioassay tubes (1 ml/tube). Three sets of controls (diet with sterilized water and sterilized production medium) were also included in the procedure to correct the mortality of larvae due to the sludge. One third-instar larva of eastern spruce budworm, kindly supplied by the Laurentian Forestry Centre (Ste-Foy, QC, Canada) was placed in each vial after the diet solidified. The vials were incubated at ambient temperature for 1 week. Samples with >10% mortality in controls were discarded and the whole procedure was repeated.
The Tx of the Bt preparation was calculated as mortality observed relative to the standard preparation and expressed in terms of billions (109) of international units of toxicity per liter (BIU/l). The standard deviation for Tx measurement was less than 5%.
Proteolytic activity assay
Proteolytic activity was determined according to Kunitz [19] with minor modifications. Samples collected from the fermentor were centrifuged at 7,650 g for 20 min at 4°C. The supernatant thus obtained was appropriately diluted with borate buffer, pH 8.2. Alkaline protease activity was assayed by incubating 1 ml diluted enzyme solution with 5 ml casein for 10 min at 37°C in a constant-temperature water-bath. The reaction was terminated by adding 5 ml 10% trichloroacetic acid (TCA). This mixture was incubated for 30 min to precipitate the total non-hydrolyzed casein. Parallel blanks were prepared with inactivated casein. At the end of the incubation period, samples and blanks were filtered through Whatman 934-AH paper. The absorbance of the filtrate was measured at 275 nm. Results were validated by treating a standard enzyme solution (Subtilisin Carlsberg, Sigma-Aldrich-Canada) of known activity in the same way and under the same conditions. One proteolytic activity unit was defined as the amount of enzyme preparation required to liberate 1 μmol (181 μg) tyrosine from casein per minute in pH 8.2 buffer at 37°C. Statistical treatment of the results showed maximum deviations of 5%.
Determination of KLa, oxygen uptake rate and OTR
The volumetric oxygen transfer coefficient (KLa) was measured in bench- and pilot plant-fermentors. In this work the measurement of KLa is based on the dynamic gassing out method [2]. KLa was determined during fermentation at the sampling times. During batch fermentation, the mass balance of the DO concentrations in the cultivation medium was defined thus:
The oxygen transfer rate \({\text{(OTR)}} = K_{\text{L}} {\text{a}}(C^* - C_{\text{L}} ),\) and \( {\text{OUR}} = Q_{{{\text{O}}_{2} }} X, \)where KL is the liquid phase mass transfer coefficient, a the gas liquid interfacial area, KLa the volumetric oxygen transfer coefficient, C* the saturated oxygen concentration, and CL the DO concentration in the medium.
OUR was measured by shutting off airflow:
Oxygen concentration in the fermentation broth was converted from % air saturation to mmol O2/l as follows: the DO electrode was calibrated in medium at 30°C and then transferred to air-saturated distilled water at known temperature and ambient pressure. This reading, together with the known saturation concentration of oxygen in distilled water (0.07559 mmol/l at 30°C) (100%), was used to estimate the saturation concentration of oxygen in cultivation medium at 30°C.
Results and discussion
Enhancement of viable cell and spore count
VC and SC profiles, Tx potential and proteolytic activity were very similar in shake flask, bench and pilot scale fermentor (Figs. 1, 2, 3). A short lag phase was observed in shake flask as well as in bench and pilot fermentors; this could be attributed to good adaptation of Bt in the pre-culture stage. The pre-culture stage allowed the bacteria to synthesize specific enzymes for the degradation of the organic matter present in sludge, and use the generated energy for cellular development [20].
Irrespective of the scale of fermentation, exponential growth occurred during the first 9–10 h (Figs. 1, 2, 3): the maximum values of specific growth rates (μmax) based on total VC count were 0.354, 0.409 and 0.569/h in shake flask, bench scale fermentor and pilot scale fermentor, respectively (Table 3). Figures 1, 2 and 3 also show that it is difficult to demarcate vegetative growth and spore production; spore concentration increased from zero time. The presence of spores in the sample drawn just after inoculation (zero time) indicated that there were spores in the inoculum. However, the increase in total VC count (spore and vegetative cells) showed that active growth continued for 9–10 h followed by a slower growth (Figs. 1, 2, 3). Exponential growth persisted for about 6 h. The VC count increased by 38–55% in the bioreactors compared to in shake flasks (Table 3). The reason for this increase might be the comparatively high μmax value and controlled conditions of pH and DO in bioreactors. The higher μmax in the fermentor could be attributed to better oxygenation capacity of the medium at the bench and pilot scale, in agreement with the conclusions of others [1, 36] working with gruel and molasses as raw material, respectively.
An increase of about 35% in SC was observed going from shake flask to fermentor experiments (Table 3). It is important to point out that sporulation was not affected by the change of scale under controlled conditions. The SC was approximately the same at bench and pilot scale (5.3–5.5 e+08 cfu/ml); this could be due to non-limiting oxygen conditions.
Enhancement of Tx potential
Tx potential was measured from 12 h of growth and showed an almost linear increase with fermentation time. Early spore production (Figs. 1, 2, 3) resulted in a concomitant increase in Tx value irrespective of scale. Tx values were not measured before 12 h; however, there could be production of Tx in the medium before 12 h along with spore production. Tx obtained at the end of active growth (12 h) was substantial, 50% of maximum (at the end of fermentation) in shake flasks and bench scale fermentors and 69% in pilot scale fermentors (Figs. 1, 2, 3). This is contrary to the findings of many authors who stated that, during exponential growth, cells do not contain the crystal toxin antigen and are nontoxic [21]. One of the reasons for this discrepancy could be slow Bt growth in the sludge medium, which might have helped the spores to mature properly and provided sufficient time for the formation of endotoxin before cell lysis occurred [33]. Aronson [5] also showed that a crystal toxin antigen appears in the cells strictly during spore engulfment (stage III) and cortex synthesis (stage IV). This could explain the substantial Tx value obtained after 24 h fermentation; Tx values were 70%, 75% and 77% in shake flask, bench scale fermentor and pilot scale fermentor, respectively (Figs. 1, 2, 3). The balance of the Tx potential appeared during the remainder of the fermentation course (24–48 h), where there was no substantial increase in SC.
The highest entomocidal activity was also found near the end of cultivation, as shown in Figs. 1, 2 and 3. A 30% improvement in Tx potential was obtained at pilot scale as compared to shake flasks. In general, the higher μmax values obtained in bench and pilot fermentors (Table 3) resulted in higher VC, SC and Tx, as fast-growing cells carry higher energy, leading to higher sporulation and Tx potency [29, 32].
Proteolytic activity
Bacillus are typical carrion dwellers—they are well adapted to digest varied and complex substrates. From the onset of sporulation, Bt synthesizes different types of proteases required to hydrolyze complex proteins in order to satisfy its nutritional needs [8, 10].
The evolution of PA produced at different production scales is illustrated in Figs. 1, 2 and 3. The maximum PA observed was 1.2 (24 h), 2.6 (36 h) and 4.1 (30 h) IU/ml in shake flask, bench and pilot scale fermentors, respectively. At all production scales, a decline in PA was recorded after attaining the maximum level. This might be due to inactivation of proteases due to interactions with other compounds in the culture medium.
PA increased by 2 and 3.4 times at bench and pilot scale, respectively, compared to the maximum activity obtained in shake flasks (Table 3). This could be due to an increase in oxygen transfer, and pH control. Tyagi et al. [30] obtained proteolytic activities in fermentors that were four times higher than those obtained in shake flasks using sewage sludge as raw material for Bt production. Meunier [22] showed that changes in pH during growth of Bt in shake flask experiments could inactivate proteolytic enzymes. Moreover, the maximum PA (4.1 IU/ml) was obtained in pilot scale without affecting the production of δ-endotoxin. These results are in line with those of Tyagi and co-workers [30], who showed that a substantial amount of alkaline proteases, as well as Bt toxins, could be produced simultaneously using sludge as raw material without affecting the Tx of the final fermentor broth. Moreover, a formulation devoid of protease offers a more stable product. Therefore, it is preferable to eliminate the protease in the supernatant by centrifugation and use the residual solids containing Bt cells, spores and endotoxin for formulation. This will reduce the negative effects of proteases in Bt formulations, and the protease in the supernatant could be recovered for further use [36, 37].
OUR, OTR and KLa pattern
Profiles of KLa, OUR, and OTR in bench and pilot scale fermentors are presented in Figs. 2 and 3, respectively. During the first stage of fermentation (first 6 h of growth), a decrease in DO was noticed due to the higher OUR resulting from active growth of Bt (exponential growth). Thereafter (10–15 h of fermentation), the oxygen consumption rate decreased and the oxygen concentration increased and remained relatively constant until the end of fermentation. In wastewater sludge media, KLa increased at the beginning of fermentation and then fluctuated somewhat irregularly during the rest of the fermentation due to changes in impeller speed and metabolite production.
Increasing the agitation and aeration rates is the traditional approach used to enhance OTR. Increased agitation produces more gas dispersion, and gas dispersion produces higher oxygen transfer [23]. However, in pilot scale, even at low stirrer speed, KLa values were higher than in bench-scale fermentors (Figs. 2, 3). This could be due to the small size of air bubbles produced due to hydrostatic pressure in the pilot-scale bioreactor. In fact, bubble characteristics have been found to strongly affect the value of KLa [15]. Juarez and Orejas [17] also found an increase in KLa with decreased bubble size.
OUR values were useful determinants of the different phases of the Bt growth cycle during batch fermentation [9]. The peaks of KLa, OUR and OTR occurred at the same time, 6 h after inoculation (Figs. 2 and 3), then dropped sharply. The sharp decrease in KLa, OUR and OTR could be identified as marking the end of the exponential growth phase. OUR and OTR in pilot scale fermentor are higher than those in bench scale (Figs. 2, 3), and this resulted in a higher specific growth rate in pilot scale (Table 3). This is in accord with the observation of Rowe et al. [24], who observed that OUR increased with μmax.
Differences in KLa, OUR and OTR between the two fermentor scales can be attributed to changes in the interfacial area (a), which is affected by the volume of liquid, liquid height in the vessel, the dimensions of the fermentation vessel, bubble size, and the pattern and vigor of agitation.
Correlation between KLa and proteolytic activity
OTR and pH are the key variables in the production of alkaline proteases [3, 18]. A correlation has been found between the KLa and PA in submerged fermentation. Oxygen transfer is enhanced at larger scales because higher superficial velocities are achieved when the dimensional ratios of the vessels are held constant [15, 27].
The increase of OTR in the pilot scale fermentor increased the PA (Figs. 2, 3). At pilot scale fermentor, aeration was achieved by a gas sparger consisting of a perforated ring located at the bottom of the reactor. This sparger supplied a smaller bubble size than the bench-scale fermentor (air supply by perforated tube). The smaller bubble size could also have been created through higher hydrostatic pressure in the pilot-scale fermentor. The benefit of small bubbles is the slow rising velocity, which keeps air bubbles in the liquid longer, allowing more time for the oxygen to dissolve [11]. Furthermore, small air bubbles provided a higher interfacial area (a) than large air bubbles [26].
Stirrer speed could also affect PA. A higher agitation rate in bench scale (300–500 rpm) compared to pilot scale (100–190 rpm), increased oxygen transfer in the vessel, but did not improve enzyme production. This could be due to strong shear rates, which could lead to deterioration of the cells and hence the enzyme yield [26].
Process performance
The weak performance (μmax,VC, SC, Tx and PA) recorded in shake flasks compared to fermentors could be explained by the fact that Bt fermentation in shake flasks presents certain limitations at the level of control of major fermentation parameters including pH, oxygen transfer, considerable evaporation and poor mixing. Humphrey [14] revealed that the cotton plug could be a factor limiting oxygen transfer.
It is clear that under controlled conditions of pH and DO, a significant enhancement of VC, SC, Tx potential and PA are observed. The differences observed between the bench and pilot-scale runs were presumably related to the mixing and flow characteristics of each fermentor. In general, the mixing time is not the same in reactors of different scale [12].
Wastewater sludge contains a large quantity of proteins, which results in intense foaming during exponential growth of Bt. However, adequate control of agitation and aeration with a well-optimized sludge solids concentration can avoid problems related to foam formation during fermentation. Higher aeration rates often encounter the problem of excessive foaming, especially during exponential growth of Bt using sludge as raw material [31].
For large-scale production of Bt, the supply of raw material is not problematic as wastewater sludge is abundantly available. However, this complex medium is characterized by an inconsistent and unknown composition, especially regarding the availability of assimilable nitrogen and carbon sources, which may lead to a great variability between fermentation batches. However, keeping the solids concentration at an optimum level of 20–25 g/l [20] in the fermentor will give a fairly constant process performance. The effect of variability of sludge composition on Bt growth and toxin synthesis was verified by collecting sludge samples from the CUQ wastewater treatment plant at different times (to cover seasonal, day and night and other possible variations) for a period of 1 year. These samples were used to grow Bt under similar conditions in shake flasks. It was found that, utilizing the optimal suspended solids concentration of 20–25 g/l, the variation in Tx value was between +9 and −13% (unpublished data). Another way to combat the variation in sludge characteristics and its consequences on fermentation could be the use of dewatered sludge. Dewatered sludge can be stored over time without changes in composition. However, dewatered sludge furnished 20% lower Tx in comparison to fresh sludge at the same solids concentration (25 g/l) [33].
In conclusion, the performance and reproducibility of the process at two different production scales has been demonstrated. The scale-up study has confirmed the optimal conditions derived from the small-scale optimization study, resulting in higher Tx potential and a high PA. Thus, this process provides solutions for safe wastewater sludge disposal and production of high potency and low cost biopesticides.
References
Abdel-Hameed A (2001) Stirred tank culture of Bacillus thuringiensis H-14 for production of the mosquitocidal δ-endotoxin: mathematical modelling and scaling-up studies. World J Microbiol Biotechnol 17:857–861
Aiba S, Humphrey AE, Millis NF (1973) Biochemical engineering, 2nd edn. Academic, New York
Anwar A, Saleemuddin M (1997) Alkaline proteases: a review. Bioresour Technol 64:175–183
APHA, AWWA, WPCF (1989) Standard methods for examination of waters and wastewaters, 17th edn. American Public Health Association, Washington DC
Aronson A (2002) Sporulation and δ-endotoxin synthesis by Bacillus thuringiensis. Cell Mol Life Sci 59:417–425
Avignone-Rossa C, Arcas J, Mignone C (1992) Bacillus thuringiensis, sporulation and δ-endotoxin production in oxygen limited and non-limited cultures. World J Microbiol Biotechnol 8:301–304
Beegle CC (1990) Bioassay methods for quantification of Bacillus thuringiensis δ-endotoxin. In: Hickle LA, Fitch WL (eds) Analytical chemistry of Bacillus thuringiensis. American Chemical Society, Washington DC, pp 14–21
Braun S (2000) Bioassays of Bacillus thuringiensis, 1D. In: Navon A, Ascher KRS (eds) Production of Bacillus thuringiensis insecticides for experimental uses. Bioassays of entomopathogenic microbes and nematodes. CAB International, Wallingford, UK, pp 49–72
Chang SW (1993) Studies of growth conditions and estimations of oxygen uptake rate for Bacillus thuringiensis. Thesis, University of Illinois, p 95
Chu IM, Lee C, Li TS (1992) Production and degradation of alkaline protease in batch culture of Bacillus subtilus ATCC 14416. Enzyme Microb Technol 14:755–761
Doran PM (1995) Bioprocess engineering principles. Academic, San Diego
Flores EA, Perez F, De La Torre M (1997) Scale-up of Bacillus thuringiensis fermentation based on oxygen transfer. J Ferment Bioeng 83:561–564
Hsu YL, Wu WT (2002) A novel approach for scaling-up a fermentation system. Biochem Eng J 11:123–130
Humphrey A (1998) Shake flasks to fermentor: what have we learned? Biotechnol Prog 14:3–7
Jin B, Leeuwen J, Doelle HW, Yu Q (1999) The influence of geometry on hydrodynamic and mass transfer characteristics in an external airlift reactor for the cultivation of filamentous fungi. World J Microbiol Biotechnol 15:73–79
Ju LK, Chase GG (1992) Improved scale-up strategies of bioreactors. Bioprocess Eng 8:49–53
Juarez P, Orejas J (2001) Oxygen transfer in a stirred reactor in laboratory scale. Latin Am Appl Res 31:433–439
Kumar CG, Takagi H (1999) Microbial alkaline proteases: from a bioindustrial viewpoint. Biotechnol Adv 17:561–594
Kunitz M (1947) Crystalline soybean trypsin inhibitor. J Gen Physiol 30:291–310
Lachhab K, Tyagi RD, Valero JR (2001) Production of Bacillus thuringiensis biopesticides using wastewater sludge as a raw material: effect of inoculum and sludge solids concentration. Process Biochem 37:197–208
Liu CM, Tzeng YM (2000) Characterization study of the sporulation kinetics of Bacillus thuringiensis. Biotechnol Bioeng 68:11–17
Meunier N (1999) Évaluation du potentiel de production de protéases bactériennes à partir de boues d’épuration municipales. Msc Thesis, INRS-Eau, Université du Québec
Parakulsuksatid P (2000) Utilization of microbubble dispersion to increase oxygen transfer in pilot scale baker’s yeast fermentation unit. MSc Thesis, University of Virginia
Rowe GE, Margaritis A, Wei N (2003) Specific oxygen uptake rate variations during batch fermentation of Bacillus thuringiensis subspecies kurstaki HD. Biotechnol Prog 19:1439–1443
Sachdeva V, Tyagi RD, Valero JR (2000) Production of biopesticides as a novel method of wastewater sludge utilization/disposal. Water Sci Technol 42:211–216
Sachidanadham R, Kumar IA, Krishnan MR, Jayaraman K (1999) Mathematical model based estimation of volumetric oxygen transfer coefficients in the production of proteolytic enzymes in Bacillus amyloliquefaciens. Bioprocess Eng 2:319–322
Schell DJ, Farmer J, Hamilton J, Lyons B, McMillan JD, Saez JC, Tholudur A (2001) Influence of operating conditions and vessel size on oxygen transfer during cellulase production. Appl Biochem Biotechnol 91:627–642
Tirado-Montiel ML, Tyagi RD, Valero JR (2001) Wastewater treatment sludge as a raw material for the production of Bacillus thuringiensis based biopesticides. Water Res 35:3807–3816
Tirado-Montiel ML, Tyagi RD, Valero JR, Surampalli RY (2003) Production biopesticides using wastewater sludge as a raw material: effect of process parameters. Water Sci Technol 48:239–246
Tyagi RD, Foko VS, Barnabe S, Vidyarthi AS, Valero JR (2002) Simultaneous production of biopesticide and alkaline proteases by Bacillus thuringiensis using sewage sludge as raw material. Water Sci Technol 46:247–254
Vidyarthi AS, Desrosiers M, Tyagi RD, Valero JR (2000) Foam control in biopesticide production from sewage sludge. J Ind Microbiol Biotechnol 25:86–92
Vidyarthi AS, Tyagi RD, Valero JR (2001) Effect of surface-active agents on the production of biopesticides using wastewater sludge as a raw material. Water Sci Technol 44:253–260
Vidyarthi AS, Tyagi RD, Valero JR, Surampalli RY (2002) Studies on the production of Bacillus thuringiensis based biopesticides using wastewater sludge as a raw material. Water Res 36:4850–4860
Yamamoto T (1982) Identification of entomocidal toxins of Bacillus thuringiensis by high performance liquid chromatography. J Gen Microbiol 129:2595–2603
Yang XM, Wang SS (1998) Development of Bacillus thuringiensis fermentation and process control from a practical perspective. Biotechnol Appl Biochem 28:95–98
Zouari N, Jaoua S (1999) Production and characterization of metalloproteases synthesized concomitantly with d-endotoxin by Bacillus thuringiensis subsp. kurstaki strain grown on gruel-based media. Enzyme Microbial Technol 25:364–371
Zouari N, Achour O, Jaoua S, (2002) Production of delta-endotoxin by Bacillus thuringiensis subsp kurstaki and overcoming of catabolite repression by using highly concentrated gruel and fish meal media in 2 and 20 dm3 fermentors. J Chem Technol Biotechnol 77:877–882
Acknowledgements
The authors are thankful to the Natural Sciences and Engineering Research Council of Canada for financial support (Grants A4984, STR 202047, SCF 192190–96 and Canada Research Chair).
Author information
Authors and Affiliations
Corresponding author
Rights and permissions
About this article
Cite this article
Yezza, A., Tyagi, R.D., Valèro, J.R. et al. Scale-up of biopesticide production processes using wastewater sludge as a raw material. J IND MICROBIOL BIOTECHNOL 31, 545–552 (2004). https://doi.org/10.1007/s10295-004-0176-z
Received:
Accepted:
Published:
Issue Date:
DOI: https://doi.org/10.1007/s10295-004-0176-z